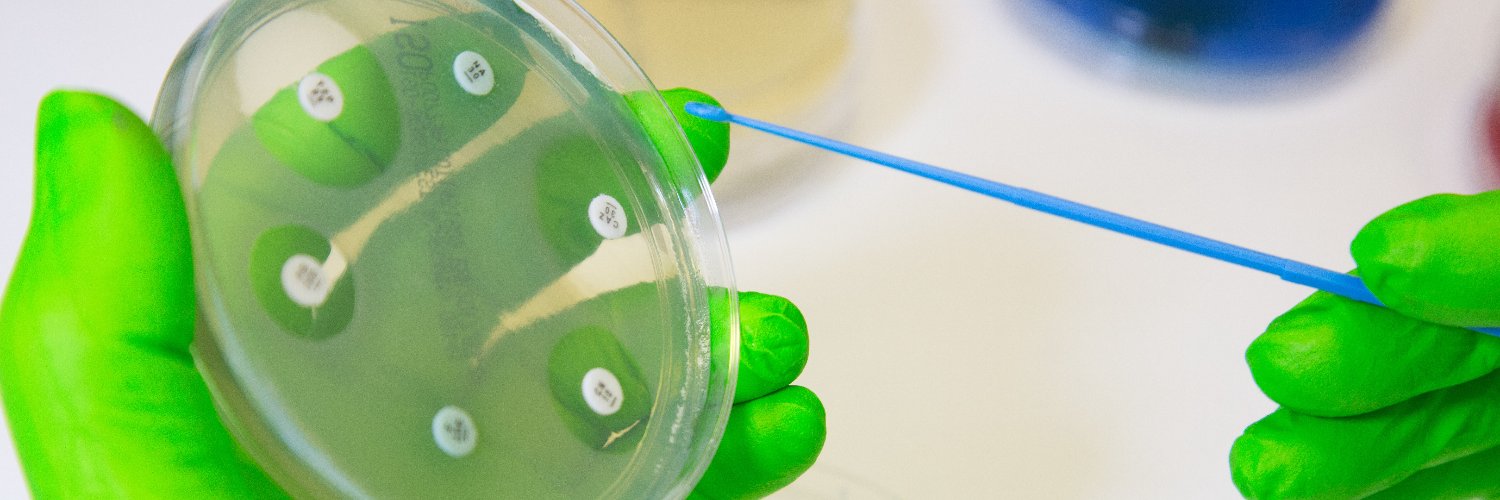
LSHTM AMR Centre banner

LSHTM AMR Centre retweetledi

📢#AMR is a growing global threat that undermines decades of medical progress.
In this blog, India's Prime Minister, @narendramodi, emphasises the urgent need for action to curb misuse and strengthen health systems to tackle #AMR.
Read more: blogs.lshtm.ac.uk/hppdebated/202…

English